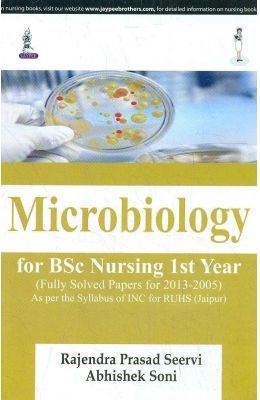
Read Online Microbiology For Bsc Nursing 1St Year (Fully Solved Papers For 2013-2005) - Seervi Rajendra Prasad | PDF

This Book Is Based On Microbiology For Bsc Nursing 1St Year (Fully Solved Papers For 2013-2005)
Read Microbiology For Bsc Nursing 1St Year (Fully Solved Papers For 2013-2005) - Seervi Rajendra Prasad file in ePub
Related searches:
According to inc syllebus in 1st year there are 9 subjects� anatomy� physiology, biochemistry� nutrition� psychology, microbiology, foundation of nursing.
Pv nursing microbiology new concept by dr lamtiyaz for bsc nursing 1st year as per inc syllabus at onlinebooksstore.
Course description: this course is designed to enable students to acquire.
Bsc nursing 1st semester syllabus course on the microbiology, the student attends classes and understands about the various micro-.
5 ratings 23151 interaction 5666 downloads� this nursing book will.
Microbiology (stereo microscope), confocal, inverted microscope, and electron microscope (tem and sem).
Dec 30, 2020 - introduction to microbiology lecture, microbiology terminologybsc nursing 1st year microbiology, bsc nursing 1st year, microbiology.
The contents of the book is based on ctevt and see syllabus on veterinary laboratory technique.
Author: surinder kumar; edition: 1st; publisher: jaypee brothers; year: 2015; isbn:.
Bsc nursing 1st year microbiology bsc nursing first year microbiology for nurses notes/book (pdf) microbiology text book (second edition) is top selling.
Post Your Comments: